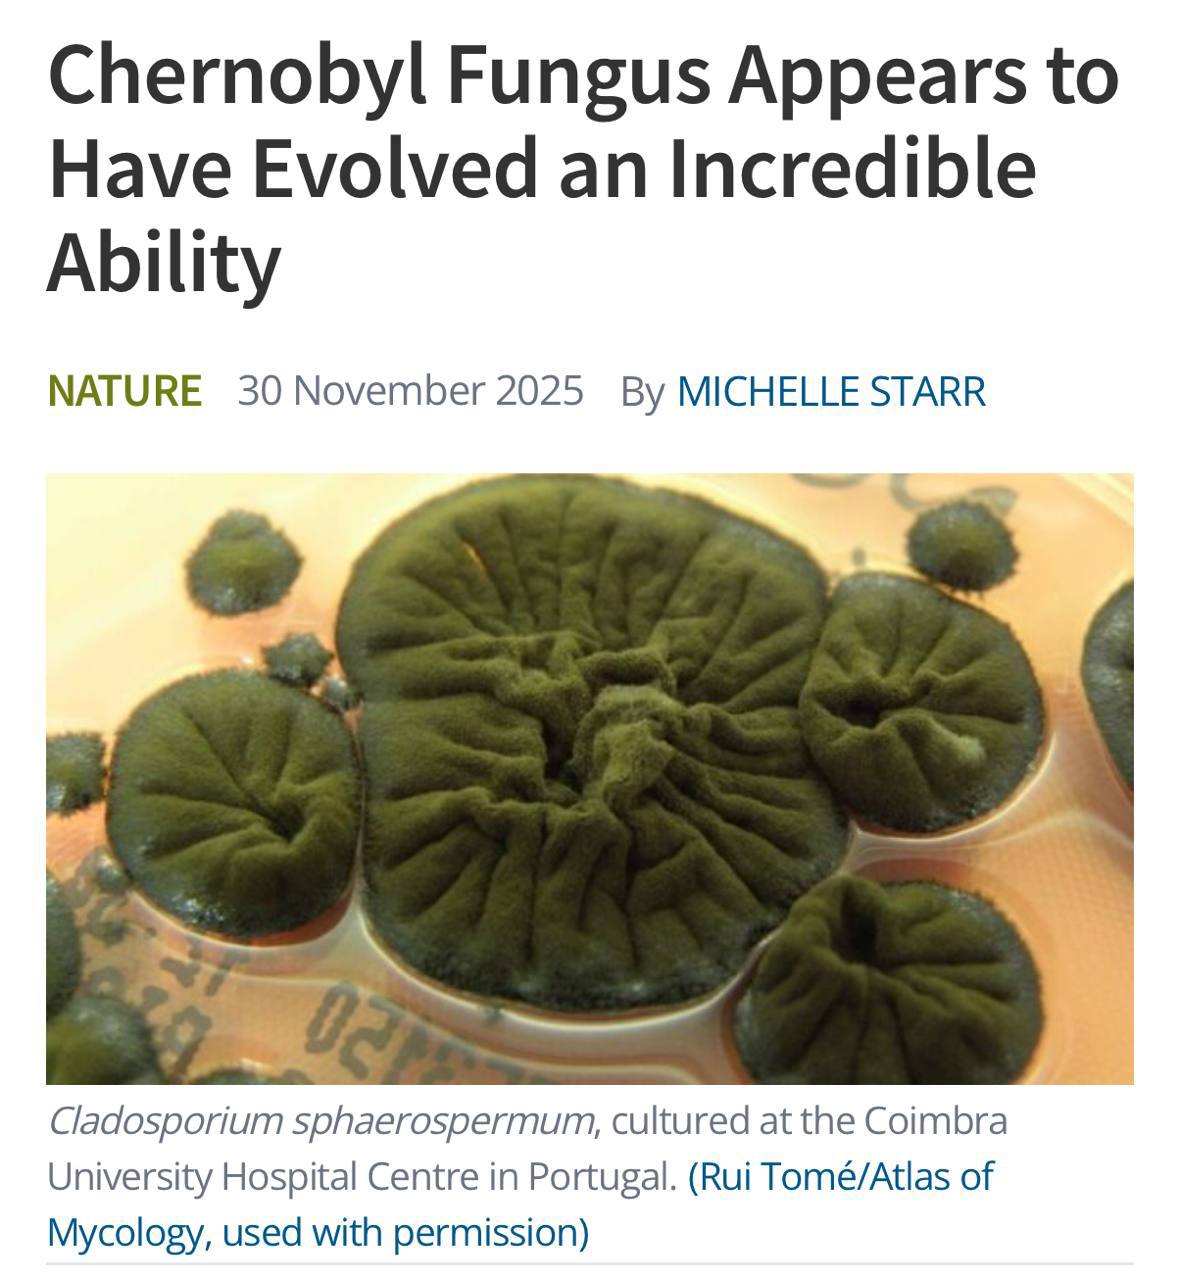
В Чернобыльской зоне обнаружили необычную форму жизни гриб Cladosporium sphaerospermum который по данным учёных способен использовать радиацию как источник энергии Он растёт прямо на стенах разрушенного реактора где уровень излучения губителен даже для бактерий Исследователи считают что меланин в его клетках может работать наподобие хлорофилла помогая организму перерабатывать излучение этот процесс называют радиосинтезом Самое поразительное то что под воздействием ионизирующего излучения гриб не просто выживает он начинает расти быстрее
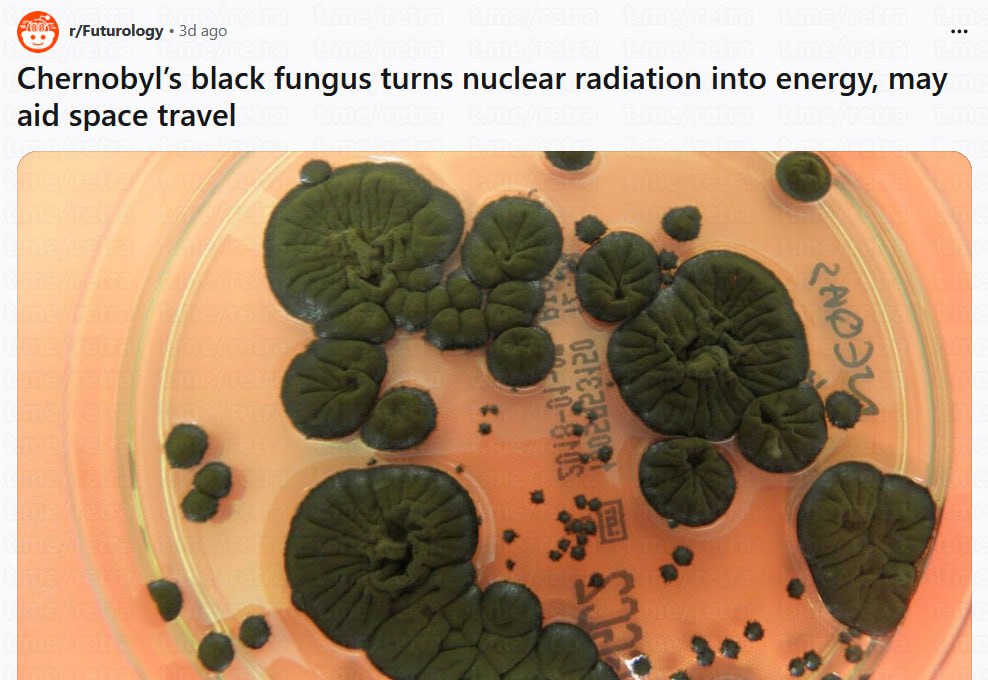
В самом сердце разрушенного ЧАЭС нашли организм которому радиация как некоторым кофе не убивает а бодрит Гриб Cladosporium sphaerospermum спокойно растёт внутри самых загрязнённых сооружений и судя по наблюдениям чувствует себя там даже лучше чем без излучения Секрет в том что в нём много меланина того самого пигмента который способен поглощать и рассеивать энергию Учёные предполагают что гриб буквально использует радиацию себе в плюс получая метаболическое преимущество Человечество строит бетонные саркофаги и свинцовые стены а природа тихо выращивает живой радиационный щит Кажется жанр постапокалиптики в играх и фильмах скоро окончательно превратится в документалку

3 декабря, 16:56
Ученые обнаружили грибок, питающийся радиацией, в Чернобыле


Тамир Шейх Здоровье Фитнес Единоборства
На территории ЧАЭС нашли уникальный грибок который не просто выдерживает экстремальную радиацию а буквально питается ею превращая в энергию Іnteresting engineering Учёные считают что это открытие способно кардинально изменить подходы к защите и строительству в космосе Они изучают грибок Cladosporium sphaerospermum который благодаря меланину способен расти под воздействием радиации и частично её поглощать На Международной космической станции его рост оказался на 20 интенсивнее чем на Земле Такой биологический щит можно выращивать прямо в космосе что делает его более лёгкой и дешёвой альтернативой традиционным защитным материалам NASA уже рассматривает концепцию микоархитектуры самовосстанавливающихся мицелиевых конструкций которые могут стать основой будущих внеземных поселений
Наука16 дней назад


Севкор z Новости Севастополя z
Чернобыльский гриб поможет в освоении космоса В зоне отчуждения Чернобыльской АЭС обнаружен гриб Cladosporium sphaerospermum способный не только выживать в условиях смертельной радиации но и использовать её как источник энергии процесс названный радиосинтезом Этот черный налет покрывающий стены реактора 4 был открыт в 1990 х микробиологом Нелли Ждановой Грибок растет быстрее под воздействием гамма излучения благодаря меланину который преобразует радиацию в химическую энергию аналогично фотосинтезу у растений Исследования 2008 и 2022 годов подтвердили C sphaerospermum поглощает радиацию как губка снижая её уровень на 2 5 в экспериментах на МКС NASA уже тестировала гриб на Международной космической станции слой толщиной 21 см блокирует до половины космической радиации В будущем его можно применять для защиты астронавтов на Марсе производства энергии в космосе и биоремедиации загрязнённых зон Севкор теперь в MAX Читайте Севкор
Наука15 дней назад


WORLD OF TECH
Грибок поглощающий радиацию Ученые обнаружили грибок на ЧАЭС который растет под радиацией и частично ее поглощает благодаря меланину Эксперименты на МКС показали что в космосе он растет на 20 быстрее Это может стать основой для будущих космических баз NASA уже рассматривает идею использования такого живого щита для защиты от радиации в космосе WORLD OF TECH ПОДПИШИСЬ
Наука14 дней назад


QWERTY
Черный грибок из Чернобыля превращает ядерную радиацию в энергию Грибок Cladosporium sphaerospermum обнаруженный в высокорадиоактивных руинах Чернобыльской АЭС обладает уникальной способностью не просто выживать но и использовать ионизирующее излучение для роста Исследования показали что секрет кроется в меланине пигменте в клеточных стенках грибка В присутствии радиоактивного цезия его рост ускоряется на 10 что указывает на процесс радиосинтеза преобразования радиации в энергию Образцы грибка отправляли и на МКС В условиях интенсивной космической радиации колония не только выжила но и росла в 1 21 раза быстрее контрольных образцов на Земле одновременно экранируя часть излучения Это означает что его можно использовать как биологическую защиту от радиации
Наука14 дней назад

Монеточка
В Чернобыльской зоне обнаружили необычную форму жизни гриб Cladosporium sphaerospermum который по данным учёных способен использовать радиацию как источник энергии Он растёт прямо на стенах разрушенного реактора где уровень излучения губителен даже для бактерий Исследователи считают что меланин в его клетках может работать наподобие хлорофилла помогая организму перерабатывать излучение этот процесс называют радиосинтезом Самое поразительное то что под воздействием ионизирующего излучения гриб не просто выживает он начинает расти быстрее
Наука13 дней назад


skidmarket.ru
Ежедневно обновляем ассортимент, чтобы вы могли покупать дешевле и лучше.
Реклама12 дней назад


Голос страны
В Чернобыле ученые нашли грибок питающийся радиацией В Чернобыле ученые обнаружили грибок живущий в местах скопления радиации В ходе исследования выяснилось что Cladosporium sphaerospermum так его величают также может и жить в обычной среде но повышенный радиационный фон ускоряет его рост Ученые предполагают что процесс питания схож с фотосинтезом Назвали необычный процесс соответствующе радиосинтез Однако точные механизмы его действия остаются неизвестными сообщает научный портал Science Alert Подписывайся на Голос страны в МАХ
Наука15 дней назад


Вилейка | Новости
Ученые обнаружили в Чернобыльской зоне уникальный гриб Cladosporium sphaerospermum который не просто выживает в условиях смертельной радиации но и активно развивается за счёт неё Гриб растёт на стенах самого радиоактивного здания реактора 4 Чернобыльской АЭС где произошёл взрыв в 1986 году Его чёрный пигмент меланин позволяет преобразовывать ионизирующее излучение в энергию по аналогии с фотосинтезом у растений Учёные назвали этот процесс радиосинтезом Эксперименты подтвердили гриб не только устойчив к радиации но и растёт быстрее при её воздействии В 2022 году гриб испытали на внешней поверхности МКС Оказалось он способен служить радиационным щитом Точный механизм радиосинтеза пока остаётся загадкой Учёные продолжают исследовать происходит ли фиксация углерода или это особая адаптация Жизнь продолжает удивлять находя способы существовать даже в самых экстремальных условиях наукавчёрнобыле радиосинтез грибы vileykaby
Наука14 дней назад


Эксплойт
В Чернобыльской зоне открыли новую форму жизни гриб Cladosporium sphaerospermum который научился питаться радиацией Гриб растёт прямо на стенах разрушенного реактора где радиация смертельна даже для бактерий Учёные предполагают что меланин в его клетках может работать как аналог хлорофилла позволяя организму использовать излучение как источник энергии Теория называется радиосинтез но доказательств полного энергетического цикла пока нет Гриб не просто выжил среди экстремального фона он растёт быстрее под ионизирующим излучением Спойлеры на 2026 год The Last of Us S T A L K E R exploitex
Наука13 дней назад

Раньше всех
В самом сердце разрушенного ЧАЭС нашли организм которому радиация как некоторым кофе не убивает а бодрит Гриб Cladosporium sphaerospermum спокойно растёт внутри самых загрязнённых сооружений и судя по наблюдениям чувствует себя там даже лучше чем без излучения Секрет в том что в нём много меланина того самого пигмента который способен поглощать и рассеивать энергию Учёные предполагают что гриб буквально использует радиацию себе в плюс получая метаболическое преимущество Человечество строит бетонные саркофаги и свинцовые стены а природа тихо выращивает живой радиационный щит Кажется жанр постапокалиптики в играх и фильмах скоро окончательно превратится в документалку
Наука13 дней назад


НЕ МОРГЕНШТЕРН
В Чернобыльской зоне нашли гриб который питается радиацией Cladosporium sphaerospermum спокойно растёт на стенах разрушенного реактора там где никакие бактерии не выдерживают Теория радиосинтеза всё ещё требует доказательств но факт остаётся фактом под ионизирующим фоном этот организм разрастается еще активнее природа снова удивляет похож на зеленый хинкали НМШ
Наука12 дней назад

Похожие новости



+7



+4



+2



+3






+3

Создание нового ядерного топлива отмечено премией Вызов 2025 года
Технологии
14 часов назад


+7
Небесные явления: алые зори в Москве и полярное сияние в Псковском районе
Общество
1 день назад


+4
Наблюдение экзопланеты WASP 121b: утечка атмосферы и миграция горячих юпитеров
Наука
10 часов назад


+2
Гид объясняет, как метан подо льдом Байкала вызывает пламя на Ольхоне
Общество
1 день назад


+3
Российские ученые разрабатывают методы измерения биологического возраста и замедления старения
Наука
14 часов назад


Подмосковье укрепляет инвестиционные позиции через международные проекты
Общество
1 день назад


+3